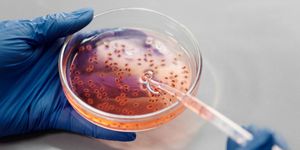

Longer Walks Lower Risk of Heart Disease and Death
A new study published in the Annals of Internal Medicine suggests that taking one long walk may be better for your health than taking several shorter walks, even if both result in the same number of steps per day.
The prospective cohort study included over 33,500 adults in the UK. All participants got less than 8,000 steps per day on average, and none of the participants had heart disease or cancer at the start of the study. The participants were grouped into categories based on how long their walks were in which they accumulated most of their steps per day: shorter than 5 minutes, 5 to 10 minutes, 10 to 15 minutes, and longer than 15 minutes. Participants were followed-up with for an average of nearly eight years, and the incidence of heart disease and all-cause mortality were tracked during this time period. While many organizations have recommended reaching a certain number of steps per day to improve health, it is unclear whether patterns of step accumulation have any impact on the heart and overall health.
The results showed that all-cause mortality during the follow-up period was directly linked to the length of walks for the participants; longer walks meant less risk of death from any cause. Participants who accumulated their steps in bouts of less than 5 minutes had a mortality risk of 4.36%, while participants who accumulated most of their steps in bouts of more than 15 minutes had a mortality risk of only 0.80%. Each intermediate category (5 to 10 minutes, 10 to 15 minutes) also showed that more steps led to less all-cause mortality risk. Heart disease risk showed an even stronger pattern, with incidence risk of 13.03% and 4.39% for those in the shortest and longest categories, respectively.
The results of this study suggest that focusing on longer walking sessions may be beneficial for the heart and overall health, especially for people who tend to be less active in general.
Sources: Annals of Internal Medicine, Science Daily